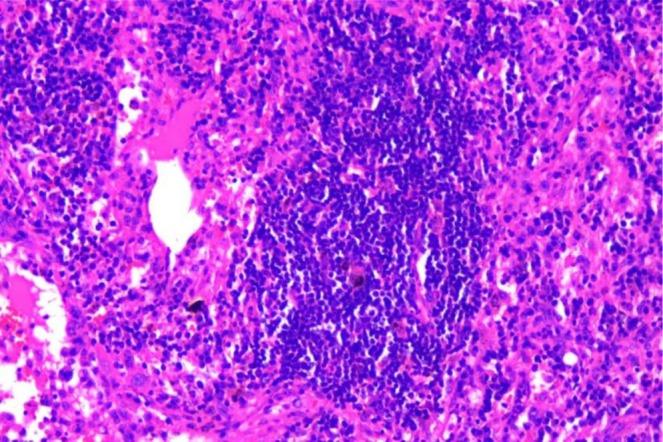

Intrathoracic Rosai-Dorfman Disease in Elderly Patients: A Case Report.
作者信息
Xiao JianFeng, Ma Li, Cao Wei
机构信息
Department of Cardiothoracic Surgery Central Hospital of Northeast Yunnan Province Zhaotong China.
出版信息
Clin Case Rep. 2025 Sep 26;13(10):e71041. doi: 10.1002/ccr3.71041. eCollection 2025 Oct.
Rosai-Dorfman disease (RDD), a rare form of histiocytosis, predominantly affects young individuals. Clinically categorized into nodal and extranodal subtypes, the disease primarily involves systemic lymph nodes with possible involvement of other organs. This variability in organ involvement leads to diverse clinical manifestations and nonspecific imaging findings, contributing to frequent diagnostic challenges and misdiagnosis. Histopathologically, the characteristic cells demonstrate S100+, CD68+, and CD1a-negative immunophenotype. We present a rare geriatric case of RDD, which may enhance diagnostic awareness and clinical management of this condition. Further research is warranted to advance our understanding of RDD pathogenesis and therapeutic strategies.